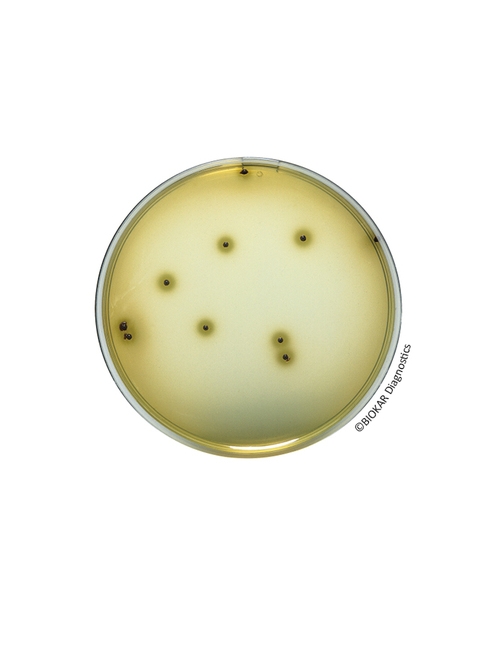
img

Bismuth Sulfite Agar (ISO 6579-1)
Bismuth Sulfite Agar (ISO 6579-1)
Bismuth Sulfite Agar ISO 6579-1, Salmonella spp. türlerini su, süt ürünleri ve diğer gıda ürünlerinde izole etmek için kullanılan seçici bir besiyeridir. Bu besiyeri, insan tüketimi ürünlerinde, hayvan yemlerinde,çevresel örneklerde ve birincil üretim aşamasındaki numunelerde özellikle Salmonella enterica alt türleri enterica serovars Typhi ve Paratyphi türlerinin saptanmasında kullanılır. Bizmut Sulfite agar, Salmonella spp. tespiti için normalize edilmiş metotlarda ikinci izolasyon agarı olarak da kullanılabilir. Tipik kompozisyon, NF EN ISO 6579-1 standartlarında tanımlanan kriterleri karşılar.
Ürün Adı: Bismuth Sulfite Agar (ISO 6579-1)
Ürün Kodu: BK223HA
Miktar: 500 g
